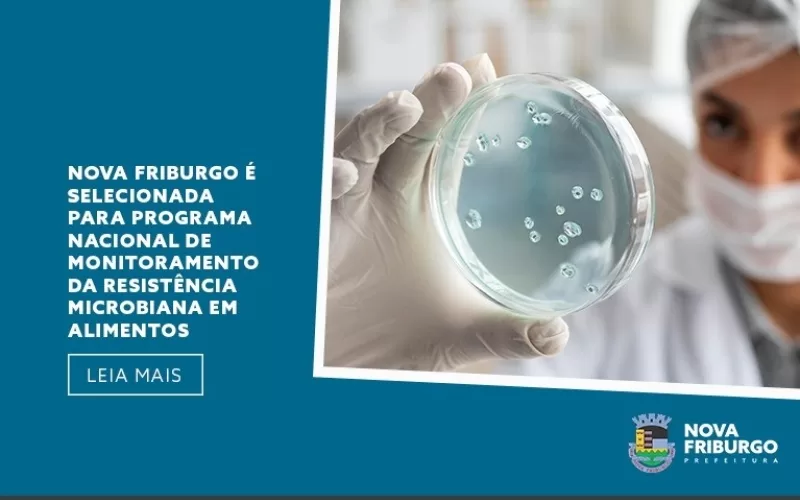

A Vigilância Sanitária de Nova Friburgo foi selecionada para integrar o Projeto Piloto do Programa Nacional de Monitoramento dos Resíduos de Antimicrobianos e Microrganismos Resistentes em Alimentos (Programa Monitora Alimentos – AMR), coordenado pela Anvisa. A iniciativa, que terá vigência no biênio 2025/2026, envolve apenas dez municípios fluminenses e reforça o reconhecimento da atuação técnica e comprometida do município na área da saúde pública.
Com foco na abordagem de Saúde Única – que integra as dimensões da saúde humana, animal e ambiental –, o Programa tem como objetivo identificar e avaliar a presença de microrganismos resistentes e resíduos de antimicrobianos em alimentos comercializados no varejo nacional. O monitoramento desses agentes é essencial para prevenir riscos à saúde da população e para subsidiar políticas públicas eficazes de enfrentamento à resistência microbiana (AMR), considerada hoje um dos maiores desafios globais de saúde pública.
A participação de Nova Friburgo nesta ação estratégica representa um avanço significativo no fortalecimento da vigilância sanitária local, contribuindo diretamente para o controle da disseminação de agentes resistentes na cadeia de alimentos, especialmente os de origem animal.
A implementação do projeto está prevista para começar no dia 1º de agosto de 2025, e será realizada em parceria com órgãos estaduais e federais, além de laboratórios oficiais de saúde pública. Essa articulação nacional reflete o compromisso do Sistema Nacional de Vigilância Sanitária (SNVS) com a promoção de alimentos mais seguros e com a proteção da saúde da população brasileira.